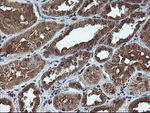
C1S Antibody in Immunohistochemistry (Paraffin) (IHC (P))

Search
OriGene
C1S Monoclonal Antibody (OTI2D11), TrueMAB™
{{$productOrderCtrl.translations['antibody.pdp.commerceCard.promotion.promotions']}}
{{$productOrderCtrl.translations['antibody.pdp.commerceCard.promotion.viewpromo']}}
{{$productOrderCtrl.translations['antibody.pdp.commerceCard.promotion.promocode']}}: {{promo.promoCode}} {{promo.promoTitle}} {{promo.promoDescription}}. {{$productOrderCtrl.translations['antibody.pdp.commerceCard.promotion.learnmore']}}
产品信息
TA504246
种属反应
宿主/亚型
分类
类型
克隆号
抗原
偶联物
形式
浓度
纯化类型
保存液
内含物
保存条件
运输条件
靶标信息
This gene encodes a serine protease, which is a major constituent of the human complement subcomponent C1. C1s associates with two other complement components C1r and C1q in order to yield the first component of the serum complement system. Defects in this gene are the cause of selective C1s deficiency.
仅用于科研。不用于诊断过程。未经明确授权不得转售。
篇参考文献 (0)
生物信息学
蛋白别名: basic proline-rich peptide IB-1; C1 esterase; Complement C1s subcomponent; Complement component 1 subcomponent s
基因别名: C1S
UniProt ID: (Human) P09871
Entrez Gene ID: (Human) 716